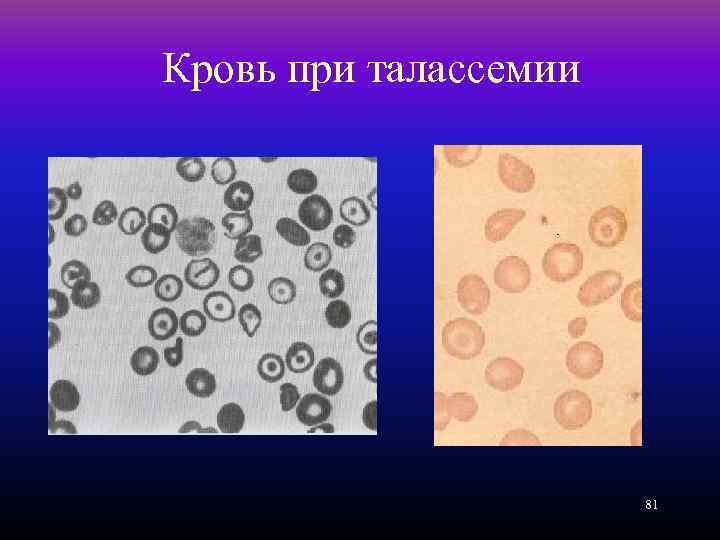
Кровь при талассемии 81

13. Анемии.ppt
- Количество слайдов: 82
 Дифференциальный диагноз анемий 1
Дифференциальный диагноз анемий 1
 Определение Анемия, или малокровие клинический синдром, связанный с уменьшением общего количества гемоглобина или эритроцитарной массы 2
Определение Анемия, или малокровие клинический синдром, связанный с уменьшением общего количества гемоглобина или эритроцитарной массы 2
 Эритропоэз ПСК – CD 34, CD 38, HLA-DR КОЕ-ГЭММ – СD 33, 34, HLA-DR БОЕ-Э (образуют бурсты – огромные колонии) – HLA I, II, CD 34, CD 33, Rh, рецепторы к ЭПО КОЕ-Э – CD 36, рецепторы к ЭПО, гликофорин А, рецепторы к ТФ 3
Эритропоэз ПСК – CD 34, CD 38, HLA-DR КОЕ-ГЭММ – СD 33, 34, HLA-DR БОЕ-Э (образуют бурсты – огромные колонии) – HLA I, II, CD 34, CD 33, Rh, рецепторы к ЭПО КОЕ-Э – CD 36, рецепторы к ЭПО, гликофорин А, рецепторы к ТФ 3
 Эритропоэз Эритробласт – CD 36, гликофорин А. Нормобласт (базофильный; полихроматофильный – не делится; оксифильный – утрачивает ядро). Ретикулоцит – теряет рецепторы к трансферрину Эритроцит – СD 35, 44, гликофорин А 4
Эритропоэз Эритробласт – CD 36, гликофорин А. Нормобласт (базофильный; полихроматофильный – не делится; оксифильный – утрачивает ядро). Ретикулоцит – теряет рецепторы к трансферрину Эритроцит – СD 35, 44, гликофорин А 4
 Свойства эритроцитов • Специфическая реакция – на сидерофильные гранулы (много – неэфф. Эритропоэз, мало – дефицит железа). • Красный росток – 25% • Разрушаются около 10% предшественников эритропоэза в костном мозге 5
Свойства эритроцитов • Специфическая реакция – на сидерофильные гранулы (много – неэфф. Эритропоэз, мало – дефицит железа). • Красный росток – 25% • Разрушаются около 10% предшественников эритропоэза в костном мозге 5
 Регуляция эритропоэза • ЭПО – вырабатывается почками, клетками моноцитарно-макрофагальной системы • Переходит под действием эритрогенина в активную форму • Регулятор – содержание кислорода в тканях • Мишень – КОЕ-Ээ • Другие регуляторы: ГМ-КСФ, ИЛ 3, ТФР-β 1, анаболики, инсулин, дексаметазон, макрофаги, фибронектин, экстрацеллюлярный матрикс 6
Регуляция эритропоэза • ЭПО – вырабатывается почками, клетками моноцитарно-макрофагальной системы • Переходит под действием эритрогенина в активную форму • Регулятор – содержание кислорода в тканях • Мишень – КОЕ-Ээ • Другие регуляторы: ГМ-КСФ, ИЛ 3, ТФР-β 1, анаболики, инсулин, дексаметазон, макрофаги, фибронектин, экстрацеллюлярный матрикс 6
 Характеристики эритроцитов • Количество Э: м 4, 6 -6, 2*1012/л, ж 4, 2 -5, 4*1012/л • Гемоглобин: м 135 -180 г/л, ж 120 -160 г/л • Средний диаметр эритроцита (MCD – mean corpuscilar diameter) 7, 5 - 8, 3 мкм • Средний объем эритроцита (MCV – mean corpuscular volume) – 80 - 95 мкм 3 (фл) • Среднее содержание гемоглобина в эритроците (MCH – mean corpuscular hemoglobin) – 27 – 31 пг • Средняя концентрация гемоглобина в эритроцитах (MCHC – mean corpuscular hemoglobin concentration) – 32 – 36 г/дл 7
Характеристики эритроцитов • Количество Э: м 4, 6 -6, 2*1012/л, ж 4, 2 -5, 4*1012/л • Гемоглобин: м 135 -180 г/л, ж 120 -160 г/л • Средний диаметр эритроцита (MCD – mean corpuscilar diameter) 7, 5 - 8, 3 мкм • Средний объем эритроцита (MCV – mean corpuscular volume) – 80 - 95 мкм 3 (фл) • Среднее содержание гемоглобина в эритроците (MCH – mean corpuscular hemoglobin) – 27 – 31 пг • Средняя концентрация гемоглобина в эритроцитах (MCHC – mean corpuscular hemoglobin concentration) – 32 – 36 г/дл 7
 Клинический анализ крови • Определение количества гемоглобина и эритроцитов - диагностика анемии • • легкая степень 110 -90 г/л средняя степень 90 -70 г/л тяжелая анемия <70 г/л крайне тяжелая анемия <51 г/л 8
Клинический анализ крови • Определение количества гемоглобина и эритроцитов - диагностика анемии • • легкая степень 110 -90 г/л средняя степень 90 -70 г/л тяжелая анемия <70 г/л крайне тяжелая анемия <51 г/л 8
 Классификация анемий • По диаметру эритроцитов • По содержанию гемоглобина в эритроцитах • По регенераторной способности костного мозга 9
Классификация анемий • По диаметру эритроцитов • По содержанию гемоглобина в эритроцитах • По регенераторной способности костного мозга 9
 Классификация по размеру эритроцитов • Микроцитарные (средний объем < 80 мкм 3) • Нормоцитарные (средний объем от 80 до 95 мкм 3) • Макроцитарные (средний объем > 95 мкм 3) • Мегалоцитарные (средний объем > 125 мкм 3 ) 10
Классификация по размеру эритроцитов • Микроцитарные (средний объем < 80 мкм 3) • Нормоцитарные (средний объем от 80 до 95 мкм 3) • Макроцитарные (средний объем > 95 мкм 3) • Мегалоцитарные (средний объем > 125 мкм 3 ) 10
 Показатели регенерации • Содержание ретикулоцитов (норма 0, 2 - 1 %) • Корригированное число ретикулоцитов – ретикулоциты*(Ht больного/Ht в норме) • Абсолютное число ретикулоцитов (норма от 20000 до 70000 в мкл). норморегенераторные анемии гиперрегенераторные анемии 11
Показатели регенерации • Содержание ретикулоцитов (норма 0, 2 - 1 %) • Корригированное число ретикулоцитов – ретикулоциты*(Ht больного/Ht в норме) • Абсолютное число ретикулоцитов (норма от 20000 до 70000 в мкл). норморегенераторные анемии гиперрегенераторные анемии 11
 Причины анемии • Нарушение продукции эритроцитов (недостаточность костного мозга, нарушение синтеза ДНК, нарушение синтеза гема) • Ускоренное разрушение эритроцитов (гемолиз) и Острая кровопотеря – ГИПЕРРЕГЕНЕРАТОРНЫЕ анемии 12
Причины анемии • Нарушение продукции эритроцитов (недостаточность костного мозга, нарушение синтеза ДНК, нарушение синтеза гема) • Ускоренное разрушение эритроцитов (гемолиз) и Острая кровопотеря – ГИПЕРРЕГЕНЕРАТОРНЫЕ анемии 12
 Недостаточность костного мозга • • Апластическая анемия Инфильтрация костного мозга Миелодиспластические синдромы Вторичные анемии (заболевания печени, заболевания почек, эндокринные болезни, хронические воспалительные заболевания) 13
Недостаточность костного мозга • • Апластическая анемия Инфильтрация костного мозга Миелодиспластические синдромы Вторичные анемии (заболевания печени, заболевания почек, эндокринные болезни, хронические воспалительные заболевания) 13
 Недостаточная продукция эритроцитов • Дефицит железа (снижение синтеза гема) • Дефицит фолиевой кислоты и витамина В 12 (снижение синтеза ДНК) • Дефицит белка 14
Недостаточная продукция эритроцитов • Дефицит железа (снижение синтеза гема) • Дефицит фолиевой кислоты и витамина В 12 (снижение синтеза ДНК) • Дефицит белка 14
 Распределение анемий по ЦП 15
Распределение анемий по ЦП 15
 Клиническая картина анемий • Общеанемический синдром • Признаки основного заболевания при вторичном характере анемии • Специфические проявления отдельных анемий (сидеропенический синдром, признаки гемолиза, неврологическая симптоматика, поражения эпителиальных тканей и др. ) 16
Клиническая картина анемий • Общеанемический синдром • Признаки основного заболевания при вторичном характере анемии • Специфические проявления отдельных анемий (сидеропенический синдром, признаки гемолиза, неврологическая симптоматика, поражения эпителиальных тканей и др. ) 16
 Физикальные данные • • Кожные покровы и слизистые Лимфаденопатия Гепатомегалия/спленомегалия Стигмы наследственных гемолитических анемий (разрастание плоских костей башенный череп, низкие надбровные дуги, полидактилия и др. ) 17
Физикальные данные • • Кожные покровы и слизистые Лимфаденопатия Гепатомегалия/спленомегалия Стигмы наследственных гемолитических анемий (разрастание плоских костей башенный череп, низкие надбровные дуги, полидактилия и др. ) 17
 Микроцитарные анемии • Гипохромные - ЖДА, талассемия, АХБ, сидеробластные • Нормохромные - гомозиготный эллиптоцитоз (редко встречается) 18
Микроцитарные анемии • Гипохромные - ЖДА, талассемия, АХБ, сидеробластные • Нормохромные - гомозиготный эллиптоцитоз (редко встречается) 18
 Железо – жизненно необходимый элемент Входит в состав гемоглобина Обеспечивает функционирование внутриклеточных ферментов (каталазы, пероксидазы) Участвует в синтезе ДНК и регуляции клеточного цикла Входит в состав миоглобина Компонент системы цитохромов, осуществляет транспорт электронов в дыхательной цепи Повышает чувствительность допаминовых рецепторов, возможно, влияет на миелинизацию нервных волокон Участвует в пролиферации Т лимфоцитов Модулирует эффекты инсулина 19
Железо – жизненно необходимый элемент Входит в состав гемоглобина Обеспечивает функционирование внутриклеточных ферментов (каталазы, пероксидазы) Участвует в синтезе ДНК и регуляции клеточного цикла Входит в состав миоглобина Компонент системы цитохромов, осуществляет транспорт электронов в дыхательной цепи Повышает чувствительность допаминовых рецепторов, возможно, влияет на миелинизацию нервных волокон Участвует в пролиферации Т лимфоцитов Модулирует эффекты инсулина 19
 Содержание железа в организме – 2, 5 -4 г (40 -50 мг/кг массы тела) Пример: ♂ массой 90 кг: 90*50=4500 мг=4, 5 г ♀ массой 60 кг: 60*40=2400 мг=2, 4 г В эритроцитах – 2500 мг, в плазме 4 мг 20
Содержание железа в организме – 2, 5 -4 г (40 -50 мг/кг массы тела) Пример: ♂ массой 90 кг: 90*50=4500 мг=4, 5 г ♀ массой 60 кг: 60*40=2400 мг=2, 4 г В эритроцитах – 2500 мг, в плазме 4 мг 20
 Вещества, влияющие на всасывание железа Увеличивают: Снижают: • Аскорбиновая к-та; танин; • Янтарная к-та; соли кальция; • Цистеин; фосфаты; • Никотинамид; фитин; • Фруктоза; фитонциды; тетрациклины; фторхинолоны
Вещества, влияющие на всасывание железа Увеличивают: Снижают: • Аскорбиновая к-та; танин; • Янтарная к-та; соли кальция; • Цистеин; фосфаты; • Никотинамид; фитин; • Фруктоза; фитонциды; тетрациклины; фторхинолоны
 Всасывание железа: 1 до 3 мг/день Нормальное всасывание железа 1 до 2 мг/день в двенадцатиперстной кишке и начальных отделах тощей кишки При повышенной потребности до 2 -3 мг/день Усвоенное железо транспортируется в печень и другие ткани Транспортный протеин: трансферрин (Tf) 24
Всасывание железа: 1 до 3 мг/день Нормальное всасывание железа 1 до 2 мг/день в двенадцатиперстной кишке и начальных отделах тощей кишки При повышенной потребности до 2 -3 мг/день Усвоенное железо транспортируется в печень и другие ткани Транспортный протеин: трансферрин (Tf) 24
 Взаимодействие с компонентами пищи Fe Fe 2+ Апикальная мембрана 2+ Fe 2+ DMT 1 Межклеточная Ft диффузия (Fe. III) Базолатеральная мембрана Fe 2+ + L (Fe 2+L) Пассивное всасывание Fe 2+ Нерастворимые комплексы (Fe 2+L) Fe 2+ H 2 O 2 Повреждение клетки –L Гепсидин Гефастин Ферропортин Fe 2+ Ft: ферритин L: лиганд DMT 1: Двухвалентный переносчик металлов 1 Fe 2+ Fe 3+ Церулоплазмин Трансферрин Оксидативный стресс!
Взаимодействие с компонентами пищи Fe Fe 2+ Апикальная мембрана 2+ Fe 2+ DMT 1 Межклеточная Ft диффузия (Fe. III) Базолатеральная мембрана Fe 2+ + L (Fe 2+L) Пассивное всасывание Fe 2+ Нерастворимые комплексы (Fe 2+L) Fe 2+ H 2 O 2 Повреждение клетки –L Гепсидин Гефастин Ферропортин Fe 2+ Ft: ферритин L: лиганд DMT 1: Двухвалентный переносчик металлов 1 Fe 2+ Fe 3+ Церулоплазмин Трансферрин Оксидативный стресс!
 Запасы железа в организме Ферритин – белок, содержащий до 4 500 ионов железа Ферритин обнаруживается во всех клетках тела Печень и селезенка – органыдепо ферритина Сывороточный ферритин содержит очень малую концентрацию железа Женщины 30 -100 мкг/л Мужчины 30 -300 мкг/л «Сборочная» субъединица ферритина Белок ферритина состоит из 24 субъединиц
Запасы железа в организме Ферритин – белок, содержащий до 4 500 ионов железа Ферритин обнаруживается во всех клетках тела Печень и селезенка – органыдепо ферритина Сывороточный ферритин содержит очень малую концентрацию железа Женщины 30 -100 мкг/л Мужчины 30 -300 мкг/л «Сборочная» субъединица ферритина Белок ферритина состоит из 24 субъединиц
 Сывороточный ферритин коррелирует с уровнем железа запаса Уровень сывороточного ферритина является достоверным индикатором количества депонированного в организме железа Падение ниже 15 мг/л означает абсолютный дефицит железа 1 мкг/л сывороточного ферритина = 10 мг депонированного железа у здорового человека 27
Сывороточный ферритин коррелирует с уровнем железа запаса Уровень сывороточного ферритина является достоверным индикатором количества депонированного в организме железа Падение ниже 15 мг/л означает абсолютный дефицит железа 1 мкг/л сывороточного ферритина = 10 мг депонированного железа у здорового человека 27
 Трансферрин – транспортная форма железа Насыщение трансферрина – показатель содержания железа в циркулирующем трансферрине (железо/ОЖСС) При насыщении < 20% недостаточно железа поступает в костный мозг и эритропоэз становится «железодефицитным» Трансферрин Степень насыщения трансферрина 24 -45 мкмоль/л 20 -45%
Трансферрин – транспортная форма железа Насыщение трансферрина – показатель содержания железа в циркулирующем трансферрине (железо/ОЖСС) При насыщении < 20% недостаточно железа поступает в костный мозг и эритропоэз становится «железодефицитным» Трансферрин Степень насыщения трансферрина 24 -45 мкмоль/л 20 -45%
 Гипохромные эритроциты Увеличение % гипохромных эритроцитов – чувствительный параметр утилизации железа в костном мозге (т. е. железо-дефицитного эритропоэза) Это прямая, количественная оценка ресурсов железа Нормальное содержание гипохромных эритроцитов в русле < 2, 5 % Содержание гипохромных эритроцитов при железо-дефицитном эритропоэзе < 10%
Гипохромные эритроциты Увеличение % гипохромных эритроцитов – чувствительный параметр утилизации железа в костном мозге (т. е. железо-дефицитного эритропоэза) Это прямая, количественная оценка ресурсов железа Нормальное содержание гипохромных эритроцитов в русле < 2, 5 % Содержание гипохромных эритроцитов при железо-дефицитном эритропоэзе < 10%
 Другие точные параметры обмена железа • Содержание гемоглобина в ретикулоцитах. • Растворимый компонент рецепторов трансферина (s. Tf. R) – независимый от наличия воспаления, опухоли, инфекционного заболевания, острого или хронического гепатита маркер обмена железа.
Другие точные параметры обмена железа • Содержание гемоглобина в ретикулоцитах. • Растворимый компонент рецепторов трансферина (s. Tf. R) – независимый от наличия воспаления, опухоли, инфекционного заболевания, острого или хронического гепатита маркер обмена железа.
 Метаболизм железа 1 до 3 мг железа абсорбируется ежедневно у здорового человека 20 -25 мг повторно используется после физиологического разрушения эритроцитов Повышение гемоглобина на 1 г/дл у мужчины весом 80 кг требует ~200 мг железа (средняя терапевтическая доза железа)
Метаболизм железа 1 до 3 мг железа абсорбируется ежедневно у здорового человека 20 -25 мг повторно используется после физиологического разрушения эритроцитов Повышение гемоглобина на 1 г/дл у мужчины весом 80 кг требует ~200 мг железа (средняя терапевтическая доза железа)
 Показатели обмена железа итог • В эритроцитах – 2500 мг, в плазме 4 мг, всасывание и потери – 1 -2 мг в сутки • Железо в сыворотке – 6 -27 мкмоль/л • ОЖСС 30 -85 мкмоль/л • Степень насыщения трансферрина железом 2045% • Трансферрин 24 -45 мкмоль/л • Ферритин сыворотки 30 -100 женщины, 30 -300 мкг/л мужчины • % гипохромных эритроцитов – 2. 5% 34
Показатели обмена железа итог • В эритроцитах – 2500 мг, в плазме 4 мг, всасывание и потери – 1 -2 мг в сутки • Железо в сыворотке – 6 -27 мкмоль/л • ОЖСС 30 -85 мкмоль/л • Степень насыщения трансферрина железом 2045% • Трансферрин 24 -45 мкмоль/л • Ферритин сыворотки 30 -100 женщины, 30 -300 мкг/л мужчины • % гипохромных эритроцитов – 2. 5% 34
 Стадии развития железодефицитной анемии 5 Стадия 1 Норма Стадия 2 Дефицит Железодефицит ная анемия железа Депо железа Транспортное железо Эритронное железо Ферритин (мкг/л) 30 -300 < 30 < 15 Насыщение трансферрина (%) 20 -45 < 20 Гемоглобин (г/дл) Crichton RR, 2006 WHO Definition 5 норма (12 -13) норма(12 -13) пониженный (< 12 -13)
Стадии развития железодефицитной анемии 5 Стадия 1 Норма Стадия 2 Дефицит Железодефицит ная анемия железа Депо железа Транспортное железо Эритронное железо Ферритин (мкг/л) 30 -300 < 30 < 15 Насыщение трансферрина (%) 20 -45 < 20 Гемоглобин (г/дл) Crichton RR, 2006 WHO Definition 5 норма (12 -13) норма(12 -13) пониженный (< 12 -13)
 Причины ЖДА • • Повышенная потребность в Fe Алиментарный дефицит Fe Хронические кровопотери Снижение всасывания Fe (мальабсорбция, ахлоргидрия, гастрэктомия, энтериты) • Нарушение всасывания железа (гипопротеинемии, врожденный дефицит трансферрина) 36
Причины ЖДА • • Повышенная потребность в Fe Алиментарный дефицит Fe Хронические кровопотери Снижение всасывания Fe (мальабсорбция, ахлоргидрия, гастрэктомия, энтериты) • Нарушение всасывания железа (гипопротеинемии, врожденный дефицит трансферрина) 36
 Признаки железодефицита • • • Изменения кожи и ее придатков Извращение вкуса Пристрастие к запахам ацетона, бензина Реже - ангулярный стоматит, гингивит Редко - глоссит, нарушение глотания, боли и тяжесть в эпигастрии; недержание мочи, мышечная слабость, боли в мышцах • Субфебрилитет • Снижение иммунитета 37
Признаки железодефицита • • • Изменения кожи и ее придатков Извращение вкуса Пристрастие к запахам ацетона, бензина Реже - ангулярный стоматит, гингивит Редко - глоссит, нарушение глотания, боли и тяжесть в эпигастрии; недержание мочи, мышечная слабость, боли в мышцах • Субфебрилитет • Снижение иммунитета 37
 Симптомы дефицита железа у детей и подростков • • Задержка роста Задержка моторного развития, координации Понижение концентрации внимания Нарушения эмоциональной сферы – застенчивость, замкнутость Утомляемость, нарушение настроения Плохая успеваемость в школе Ожирение Нарушения аппетита
Симптомы дефицита железа у детей и подростков • • Задержка роста Задержка моторного развития, координации Понижение концентрации внимания Нарушения эмоциональной сферы – застенчивость, замкнутость Утомляемость, нарушение настроения Плохая успеваемость в школе Ожирение Нарушения аппетита
 Показатель Норма Функциональ- Абсолютный дефицит Железо, мкмоль/л 6 -27 Норма/↑ Снижено Трансферрин, мкмоль/л 25 -45 Норма/↓ Повышен %нас. трансферрина 20 -45 ↓ Снижен Ферритин, мкг/л 100 -300 Норма/↑ Снижен 39
Показатель Норма Функциональ- Абсолютный дефицит Железо, мкмоль/л 6 -27 Норма/↑ Снижено Трансферрин, мкмоль/л 25 -45 Норма/↓ Повышен %нас. трансферрина 20 -45 ↓ Снижен Ферритин, мкг/л 100 -300 Норма/↑ Снижен 39
 Роль цитокинов в развитии железодефицита Провоспалительные цитокины Депонирование железа макрофагами в виде ферритина Усиление связывания трансферрина Tf. R на макрофагах Гепсидин Ингибирование ферропортина (энтероциты, макрофаги) Снижение поступления железа в кровоток Увеличение поступления железа в макрофаг через влияние на двухвалентный металлотранспортер DMT-1 40
Роль цитокинов в развитии железодефицита Провоспалительные цитокины Депонирование железа макрофагами в виде ферритина Усиление связывания трансферрина Tf. R на макрофагах Гепсидин Ингибирование ферропортина (энтероциты, макрофаги) Снижение поступления железа в кровоток Увеличение поступления железа в макрофаг через влияние на двухвалентный металлотранспортер DMT-1 40
 Картина крови при ЖДА 41
Картина крови при ЖДА 41
 42
42
 Анемии хронических болезней (АХБ) Вторичный синдром, сопровождающий длительно текущие инфекционные, системные и онкологические заболевания и характеризующийся сниженной продукцией эритроцитов и нарушением реутилизации железа из макрофагов 43
Анемии хронических болезней (АХБ) Вторичный синдром, сопровождающий длительно текущие инфекционные, системные и онкологические заболевания и характеризующийся сниженной продукцией эритроцитов и нарушением реутилизации железа из макрофагов 43
 Изменения в анализе крови при АХБ • Гипохромия и микроцитоз в поздних стадиях и при тяжелой анемизации (до этого - нормохромные нормоцитарные) • Железо и ОЖСС снижены • Ферритин повышен 44
Изменения в анализе крови при АХБ • Гипохромия и микроцитоз в поздних стадиях и при тяжелой анемизации (до этого - нормохромные нормоцитарные) • Железо и ОЖСС снижены • Ферритин повышен 44
 Сидеробластные анемии • Нарушение использования железа в связи с нарушением синтеза порфирина • Высокое содержание железа • Снижение ОЖСС • Гемосидероз • Гипохромия эритроцитов • Увеличение количества сидеробластов в костном мозге 45
Сидеробластные анемии • Нарушение использования железа в связи с нарушением синтеза порфирина • Высокое содержание железа • Снижение ОЖСС • Гемосидероз • Гипохромия эритроцитов • Увеличение количества сидеробластов в костном мозге 45
 Сидеробластные анемии • • Наследственные Приобретенные первичные вторичные - лекарственные (изониазид, азатиоприн) - токсические (свинцовые, алкогольные) 46
Сидеробластные анемии • • Наследственные Приобретенные первичные вторичные - лекарственные (изониазид, азатиоприн) - токсические (свинцовые, алкогольные) 46
 Сидеробластные анемии • Ассоциированные (при инфекциях, ревматоидном артрите, онкологических заболеваниях, уремии, микседеме, порфирии, гематологических заболеваниях - МДС, лейкозы, мегалобластные анемии) • Идиопатические 47
Сидеробластные анемии • Ассоциированные (при инфекциях, ревматоидном артрите, онкологических заболеваниях, уремии, микседеме, порфирии, гематологических заболеваниях - МДС, лейкозы, мегалобластные анемии) • Идиопатические 47
 48
48
 49
49
 Макроцитарные анемии Нормо/гипорегенераторные: • Гипо/апластические • Миелодиспластические синдромы (МДС) • Мегалобластные (дефекты синтеза ДНК) Гиперрегенераторные • Гемолитические анемии • Острая кровопотеря 50
Макроцитарные анемии Нормо/гипорегенераторные: • Гипо/апластические • Миелодиспластические синдромы (МДС) • Мегалобластные (дефекты синтеза ДНК) Гиперрегенераторные • Гемолитические анемии • Острая кровопотеря 50
 Метаболизм кобаламина и фолиевой кислоты 51
Метаболизм кобаламина и фолиевой кислоты 51
 Обмен В 12 • Высвобождение в желудке из пищи • Связывание с транскобаламинами (Rбелками) • Разрушение R-белков трипсином • Связывание с внутренним фактором Кастла • Всасывание в терминальной части подвздошной кишки • Транспортировка в связи с транскобаламином II 52
Обмен В 12 • Высвобождение в желудке из пищи • Связывание с транскобаламинами (Rбелками) • Разрушение R-белков трипсином • Связывание с внутренним фактором Кастла • Всасывание в терминальной части подвздошной кишки • Транспортировка в связи с транскобаламином II 52
 Обмен фолиевой кислоты • Поступление с пищей в виде полиглютамата • Деконъюгация в тощей кишке до моноглютамата • Всасывание в подвздошной кишке 53
Обмен фолиевой кислоты • Поступление с пищей в виде полиглютамата • Деконъюгация в тощей кишке до моноглютамата • Всасывание в подвздошной кишке 53
 Причины дефицита витамина В 12 • Строгая вегетарианская диета (редко) • Нарушение секреции внутреннего фактора Кастла (антитела, гастрэктомия) • Нарушение всасывания (синдром Золлингера. Эллисона, гипертиреоз, заболевания поджелудочной железы, заболевания подвздошной кишки, целиакия, врожденный дефицит внутреннего фактора Кастла, синдром Иммерслунд-Гресбека) • Конкурентный расход • Медикаменты (NO, противоязвенные, бигуаниды) 54
Причины дефицита витамина В 12 • Строгая вегетарианская диета (редко) • Нарушение секреции внутреннего фактора Кастла (антитела, гастрэктомия) • Нарушение всасывания (синдром Золлингера. Эллисона, гипертиреоз, заболевания поджелудочной железы, заболевания подвздошной кишки, целиакия, врожденный дефицит внутреннего фактора Кастла, синдром Иммерслунд-Гресбека) • Конкурентный расход • Медикаменты (NO, противоязвенные, бигуаниды) 54
 Причины дефицита фолиевой кислоты • Алиментарный • Повышенная потребность (беременность, лактация, гемолиз, быстрый рост опухоли, дерматит, гемодиализ, недоношенность) • Мальабсорбция, прием противосудорожных препаратов • Нарушения тканевого метаболизма (алкоголь, сульфосалазин, триметоприм, триамтерен, пириметамин, пентамидин, метатрексат, 55 дефицит В 12)
Причины дефицита фолиевой кислоты • Алиментарный • Повышенная потребность (беременность, лактация, гемолиз, быстрый рост опухоли, дерматит, гемодиализ, недоношенность) • Мальабсорбция, прием противосудорожных препаратов • Нарушения тканевого метаболизма (алкоголь, сульфосалазин, триметоприм, триамтерен, пириметамин, пентамидин, метатрексат, 55 дефицит В 12)
 Клинические проявления • Бледно-желтушная окраска кожи и склер (гемолиз) • Гиперпигментация (повышение синтеза меланина) • Афтозный стоматит, глоссит, хейлит • Мальабсорбция • Неврологические проявления • Иногда - психические нарушения • Повышение риска кардиоваскулярных заболеваний • Повышение риска раковых опухолей (фолиевая кислота) 56
Клинические проявления • Бледно-желтушная окраска кожи и склер (гемолиз) • Гиперпигментация (повышение синтеза меланина) • Афтозный стоматит, глоссит, хейлит • Мальабсорбция • Неврологические проявления • Иногда - психические нарушения • Повышение риска кардиоваскулярных заболеваний • Повышение риска раковых опухолей (фолиевая кислота) 56
 57
57
 58
58
 Диагностика • Стернальная пункция - мегалобластный тип кроветворения, уменьшение числа и укрупнение ретикулоцитов • В мазке - гиперсегментация ядер нейтрофилов, остатки ядер в эритроцитах • Нейтропения, тромбоцитопения • Содержание кобаламина в сыворотке • Содержание фолата в сыворотке и эритроцитах • Повышение метилмалоновой кислоты (В 12 -деф. Анемия) в крови и моче • Повышение гомоцистеина в крови и моче • Проба Шиллинга (В 12) • Нагрузочный тест с гистидином (фолиевая кислота) • МРТ спинного мозга 59
Диагностика • Стернальная пункция - мегалобластный тип кроветворения, уменьшение числа и укрупнение ретикулоцитов • В мазке - гиперсегментация ядер нейтрофилов, остатки ядер в эритроцитах • Нейтропения, тромбоцитопения • Содержание кобаламина в сыворотке • Содержание фолата в сыворотке и эритроцитах • Повышение метилмалоновой кислоты (В 12 -деф. Анемия) в крови и моче • Повышение гомоцистеина в крови и моче • Проба Шиллинга (В 12) • Нагрузочный тест с гистидином (фолиевая кислота) • МРТ спинного мозга 59
 Мегалобластный тип кроветворения 60
Мегалобластный тип кроветворения 60
 Кровь при В-12 дефицитной анемии 61
Кровь при В-12 дефицитной анемии 61
 62
62
 Причины мегалобластного кроветворения • Миелодиспластические синдромы • Острый эритролейкоз • Применение ингибиторов синтеза ДНК (цитостатиков) • Применение зидовудина и ацикловира 63
Причины мегалобластного кроветворения • Миелодиспластические синдромы • Острый эритролейкоз • Применение ингибиторов синтеза ДНК (цитостатиков) • Применение зидовудина и ацикловира 63
 Причины немегалобластного макроцитоза • Заболевания печени • Злоупотребление алкоголем • Гипотиреоз Причина - патология липидов клеточных мембран эритроцитов 64
Причины немегалобластного макроцитоза • Заболевания печени • Злоупотребление алкоголем • Гипотиреоз Причина - патология липидов клеточных мембран эритроцитов 64
 Причины панцитопений • • • Миелодиспластические синдромы Апластические анемии Пароксизмальная ночная гемоглобинурия Острые лейкозы Лимфомы Инфекции (микобактерии, легионелла, лихорадка Ку) • Голодание • Гипотиреоз • Гиперспленизм 65
Причины панцитопений • • • Миелодиспластические синдромы Апластические анемии Пароксизмальная ночная гемоглобинурия Острые лейкозы Лимфомы Инфекции (микобактерии, легионелла, лихорадка Ку) • Голодание • Гипотиреоз • Гиперспленизм 65
 Общие признаки гемолиза • Полихроматофилия эритроцитов • Повышение уровня ретикулоцитов • Эритроидная гиперплазия костного мозга 66
Общие признаки гемолиза • Полихроматофилия эритроцитов • Повышение уровня ретикулоцитов • Эритроидная гиперплазия костного мозга 66
 Признаки внутриклеточного гемолиза • Увеличение несвязанного билирубина в сыворотке крови • Увеличение селезенки и/или печени • Увеличение стеркобилина в кале • Увеличение уробилина в моче 67
Признаки внутриклеточного гемолиза • Увеличение несвязанного билирубина в сыворотке крови • Увеличение селезенки и/или печени • Увеличение стеркобилина в кале • Увеличение уробилина в моче 67
 Признаки внутрисосудистого гемолиза • Снижение содержания гаптоглобина • Снижение содержания гемопексина • Появление свободного гемоглобина в крови • При тяжелом гемолизе в крови метгемальбумин • В моче: ферритин и гемосидерин, гемоглобин (ОПН) 68
Признаки внутрисосудистого гемолиза • Снижение содержания гаптоглобина • Снижение содержания гемопексина • Появление свободного гемоглобина в крови • При тяжелом гемолизе в крови метгемальбумин • В моче: ферритин и гемосидерин, гемоглобин (ОПН) 68
 Признаки хронического гемолиза • Эпизоды желтухи в анамнезе • Типичные изменения лица и скелета (у молодых лиц) • Образование пигментных камней в желчном пузыре • Перегрузка железом (гемосидероз) 69
Признаки хронического гемолиза • Эпизоды желтухи в анамнезе • Типичные изменения лица и скелета (у молодых лиц) • Образование пигментных камней в желчном пузыре • Перегрузка железом (гемосидероз) 69
 Классификация гемолитических анемий • Наследственные мембранопатии гемоглобинопатии энзимопатии (ферментопатии) • Приобретенные иммунные неиммунные 70
Классификация гемолитических анемий • Наследственные мембранопатии гемоглобинопатии энзимопатии (ферментопатии) • Приобретенные иммунные неиммунные 70
 Ключевые моменты диагностики гемолитических анемий • Чаще всего встречаются приобретенные, из них - аутоиммунные гемолитические анемии • Причины внутрисосудистого гемолиза: ДВС-синдром, отравление уксусной кислотой, укусы змей, механический гемолиз, гипофосфатемия, малярия, гемолитические кризы 71
Ключевые моменты диагностики гемолитических анемий • Чаще всего встречаются приобретенные, из них - аутоиммунные гемолитические анемии • Причины внутрисосудистого гемолиза: ДВС-синдром, отравление уксусной кислотой, укусы змей, механический гемолиз, гипофосфатемия, малярия, гемолитические кризы 71
 Ключевые моменты диагностики гемолитических анемий • Причины иммунных гемолитических анемий: СКВ, антифосфолипидный синдром, лимфопролиферативные заболевания, парапротеинемии, опухоли, лекарства, микоплазма пневмонии, вирус Эпштейна-Барр • Аутоиммунные гемолитические анемии положительный прямой тест Кумбса (Ig и комплемент на эритроцитах) 72
Ключевые моменты диагностики гемолитических анемий • Причины иммунных гемолитических анемий: СКВ, антифосфолипидный синдром, лимфопролиферативные заболевания, парапротеинемии, опухоли, лекарства, микоплазма пневмонии, вирус Эпштейна-Барр • Аутоиммунные гемолитические анемии положительный прямой тест Кумбса (Ig и комплемент на эритроцитах) 72
 Ключевые моменты диагностики гемолитических анемий • Микроангиопатическая гемолитическая анемия: ДВС, механический гемолиз, тромботическая тромбоцитопеническая пурпура, HELLP-синдром, метастазы опухолей в легкие, циклоспорин - в мазке крови присутствуют каскообразные эритроциты (шистоциты) 73
Ключевые моменты диагностики гемолитических анемий • Микроангиопатическая гемолитическая анемия: ДВС, механический гемолиз, тромботическая тромбоцитопеническая пурпура, HELLP-синдром, метастазы опухолей в легкие, циклоспорин - в мазке крови присутствуют каскообразные эритроциты (шистоциты) 73
 Мембранопатии • Наследственные гемолитические анемии • Наследственный сфероцитоз анемия, спленомегалия, сфероциты, снижение осмотической резистентности эритроцитов • Другие - редко 74
Мембранопатии • Наследственные гемолитические анемии • Наследственный сфероцитоз анемия, спленомегалия, сфероциты, снижение осмотической резистентности эритроцитов • Другие - редко 74
 Микросфероцитоз 75
Микросфероцитоз 75
 Энзимопатии • Дефицит глюкозо-6 -фосфат дегидрогеназы сцеплен с Х-хромосомой • Гемолиз вызывается оксидантами (ацидоз, инфекции, токсины, лекарства сульфаниламиды, противомалярийные, левомицетин, противотуберкулезные, фенацетин, аспирин в высоких дозах и др. ) • Преципитация гемоглобина (тельца Гейнца) • «Надкусанные» эритроциты 76
Энзимопатии • Дефицит глюкозо-6 -фосфат дегидрогеназы сцеплен с Х-хромосомой • Гемолиз вызывается оксидантами (ацидоз, инфекции, токсины, лекарства сульфаниламиды, противомалярийные, левомицетин, противотуберкулезные, фенацетин, аспирин в высоких дозах и др. ) • Преципитация гемоглобина (тельца Гейнца) • «Надкусанные» эритроциты 76
 Гемоглобинопатии • Диагноз ставится по электрофорезу гемоглобина: аномальные гемоглобины или снижение нормальных гемоглобинов • Характерно поражение африканцев/жителей Средиземноморья • Серповидно-клеточная болезнь - замена в 6 -м положении β-цепи глутаминовой к-ты валином 77
Гемоглобинопатии • Диагноз ставится по электрофорезу гемоглобина: аномальные гемоглобины или снижение нормальных гемоглобинов • Характерно поражение африканцев/жителей Средиземноморья • Серповидно-клеточная болезнь - замена в 6 -м положении β-цепи глутаминовой к-ты валином 77
 Талассемия • Талассемия - ! гипохромная и микроцитарная анемия, характерны мишеневидные эритроциты. Степень гемолиза зависит от вида и тяжести дефицита цепей глобина • Малая β 0 (единичная мутация одной хромосомы из пары 11) - умеренная анемия повышение Hb. A 2 и Hb. F, снижение Hb. A 1 • Большая β+ (гомозиготная мутация): клинические проявления хронического внутриклеточного гемолиза – отсутствие 78 Hb. A 1
Талассемия • Талассемия - ! гипохромная и микроцитарная анемия, характерны мишеневидные эритроциты. Степень гемолиза зависит от вида и тяжести дефицита цепей глобина • Малая β 0 (единичная мутация одной хромосомы из пары 11) - умеренная анемия повышение Hb. A 2 и Hb. F, снижение Hb. A 1 • Большая β+ (гомозиготная мутация): клинические проявления хронического внутриклеточного гемолиза – отсутствие 78 Hb. A 1
 Альфа-талассемии 79
Альфа-талассемии 79
 80
80
Кровь при талассемии 81
Кровь при талассемии 81
 Кости черепа при талассемии 82
Кости черепа при талассемии 82
 Нормоцитарные анемии • • Апластические анемии Инфильтрация костного мозга/миелофиброз МДС Вторичные анемии (АХБ, ХПН, заболевания печени, эндокринные заболевания, гиперспленизм) • Гиперрегенераторные анемии - гемолиз, острая кровопотеря 83
Нормоцитарные анемии • • Апластические анемии Инфильтрация костного мозга/миелофиброз МДС Вторичные анемии (АХБ, ХПН, заболевания печени, эндокринные заболевания, гиперспленизм) • Гиперрегенераторные анемии - гемолиз, острая кровопотеря 83
 84
84
 Парциальная красноклеточная аплазия 85
Парциальная красноклеточная аплазия 85
 Аплазия костного мозга (трепанобиоптат) 86
Аплазия костного мозга (трепанобиоптат) 86


